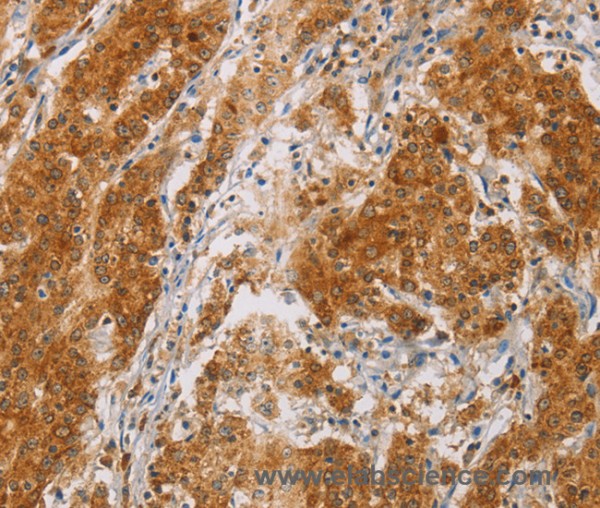
Anti-CENPE

Cookie preferences
This website uses cookies, which are necessary for the technical operation of the website and are always set. Other cookies, which increase the comfort when using this website, are used for direct advertising or to facilitate interaction with other websites and social networks, are only set with your consent.
Configuration
Technically required
These cookies are necessary for the basic functions of the shop.
"Allow all cookies" cookie
"Decline all cookies" cookie
CSRF token
Cookie preferences
Currency change
Customer-specific caching
FACT-Finder tracking
Individual prices
Selected shop
Session
Comfort functions
These cookies are used to make the shopping experience even more appealing, for example for the recognition of the visitor.
Note
Show the facebook fanpage in the right blod sidebar
Statistics & Tracking
Affiliate program
Conversion and usertracking via Google Tag Manager
Track device being used
If you have any questions, please use our Contact Form.
You can also order by e-mail: info@biomol.com
Larger quantity required? Request bulk
You can also order by e-mail: info@biomol.com
Larger quantity required? Request bulk
Centrosome-associated protein E is a kinesin-like motor protein that accumulates in the G2 phase... more
Product information "Anti-CENPE"
Centrosome-associated protein E is a kinesin-like motor protein that accumulates in the G2 phase of the cell cycle. Unlike other centrosome-associated proteins, it is not present during interphase and first appears at the centromere region of chromosomes during prometaphase. CENPE is proposed to be one of the motors responsible for mammalian chromosome movement and/or spindle elongation. Protein function: Microtubule plus-end-directed kinetochore motor which plays an important role in chromosome congression, microtubule- kinetochore conjugation and spindle assembly checkpoint activation. Drives chromosome congression (alignment of chromosomes at the spindle equator resulting in the formation of the metaphase plate) by mediating the lateral sliding of polar chromosomes along spindle microtubules towards the spindle equator and by aiding the establishment and maintenance of connections between kinetochores and spindle microtubules (PubMed:7889940, PubMed:23891108, PubMed:25395579). The transport of pole-proximal chromosomes towards the spindle equator is favored by microtubule tracks that are detyrosinated (PubMed:25908662). Acts as a processive bi-directional tracker of dynamic microtubule tips, after chromosomes have congressed, continues to play an active role at kinetochores, enhancing their links with dynamic microtubule ends (PubMed:23955301). Suppresses chromosome congression in NDC80-depleted cells and contributes positively to congression only when microtubules are stabilized (PubMed:25743205). Plays an important role in the formation of stable attachments between kinetochores and spindle microtubules (PubMed:17535814) The stabilization of kinetochore-microtubule attachment also requires CENPE-dependent localization of other proteins to the kinetochore including BUB1B, MAD1 and MAD2. Plays a role in spindle assembly checkpoint activation (SAC) via its interaction with BUB1B resulting in the activation of its kinase activity, which is important for activating SAC. Necessary for the mitotic checkpoint signal at individual kinetochores to prevent aneuploidy due to single chromosome loss. [The UniProt Consortium]
| Keywords: | Anti-CENPE, Anti-CENP-E, Anti-Kinesin-7, Anti-Centromere protein E, Anti-Kinesin-related protein CENPE, Anti-Centromere-associated protein E, CENPE Polyclonal Antibody |
| Supplier: | Elabscience |
| Supplier-Nr: | E-AB-16335 |
Properties
| Application: | IHC, ELISA |
| Antibody Type: | Polyclonal |
| Conjugate: | No |
| Host: | Rabbit |
| Species reactivity: | human, mouse |
| Immunogen: | Synthetic peptide of human CENPE |
| Format: | Purified |
Database Information
| KEGG ID : | K11498 | Matching products |
| UniProt ID : | Q02224 | Matching products |
| Gene ID : | GeneID 1062 | Matching products |
Handling & Safety
| Storage: | -20°C |
| Shipping: | 4°C (International: -20°C) |
Caution
Our products are for laboratory research use only: Not for administration to humans!
Our products are for laboratory research use only: Not for administration to humans!
Information about the product reference will follow.
more
You will get a certificate here
Viewed